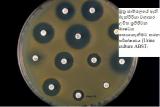

දරුවන්ගේ මුත්රා මාර්ගයේ ඇතිවන විෂ බිජ තත්වයන් ( දෙමව්පියන් දැනුවත් විය යුතු දේ)
මුත්රා මාර්ගය යනුවෙන් හැදින් වෙන්නේ ශරීරයේ කවර කොටසක්ද?
මුත්රාවල විෂබීජ තත්වයක් යනුවෙන් කුමක් අදහස් කෙරේද?
මෙය මුත්රාමාර්ගයේ හා මුත්රාවල ඇතිවන විෂබීජ තත්වයකි.
සාමාන්යයෙන් මුත්රාවලට විෂබීජ ඇතුලු වූ වහාම මුත්රාකරනවිට පිටවීම සිදුවේ.
නමුත් සමහර අවස්ථාවලදී නෙයෙකුත් හේතු නිසා මෙම විෂබීජ ඉතිරිවීම සිදුවිය හැක.
එවැනි අවස්ථාවලදී රෝග ලක්ෂණ ඇතිවීය හැක.
මෙම විෂබීජ බොහෝවිට බැක්ටීරියාවන්වේ.
එම බැක්ටීරියාවන් බොහෝවිට මලපහවල දැකිය හැකි වර්ගයන් වේ.
මුත්රාවල විෂබීජ තත්ව ඇතිකිරීමට තුඩු දිය හැකි සාධක මොනවාද?
මුත්රා නොකර බොහෝ වේලාවක් තදකරගෙන සිටීම.
වතුර බොන ප්රමාණය අඩුවීම නිසා පිටකරන මුත්රා ප්රමාණය අඩුවීම.
මලබද්ධය නිසා සිදුවන ගුදයේ මලපහ එකතුවීමත් එමගින් ඇතිකරන තෙරපීමත් නිසා මුත්රාපිට නොවී එකතු වීම.
මුත්රමාර්ගය ආශ්රිතව ඇතිවන වර්ධනයේ අසාමාන්යතා.
මුත්රාවලවිෂබීජ තත්ව වලදී ඇතිවිය හැකි රෝග ලක්ෂණ මොනවාද?
සමහර ලමුන්ට කිසිම රෝග ලක්ෂණයක් ඇතිනොවී තිබිය හැක.
රෝගි ලක්ෂණ ඇති අවස්ථාවලදී
කුඩා දරුවන් නොනවත්වා ඇඩීම.
වෙව්ලා උණ ගැනීම.
මුත්රාකරන විට දැවිල්ල ඇතිවීම.
නිතර මුත්රාපිටවීම හා ඒවා බොර පැහැයක් ගැනීම.
වරකට ඉතා ස්වල්ප වශයෙන් මුත්රා පිටවීම.
වමනය යාම.
කෑම අරුචිය,
කොන්දේ ඉල ඇටවලට පහල ප්රදේශයේ කැක්කුම ඇතිවීම.
දරුවාගේ ශරීර වර්ධනය බාලවීම.
වෛද්යවරයෙකු වෙත යොමු විය යුත්තේ කවර අවස්ථාවලදීද?
ඉහත සදහන්කල රෝගලක්ෂණ ඇත්නම් වහාම වෛද්යවරයෙකු වෙත යොමු වීමෙන් ඇතිවිය හැකි ව්යාකූලතා අවමකරගත හැක.
මේ සදහා පරීක්ෂාකරනු ලබන්නේ කෙසේද?
මූලිකවම සිදුකරන්නේ මුත්රා පරීක්ෂනයකි.
බොහෝවිට මුත්රා සාම්පලයහි ඇති බැක්ටීරියාවන් අන්වීක්ෂය ආධාරයෙන් හදුනාගත හැක.
එසේ නොමැති අවස්ථාවලදී විශේෂිත මාධ්යයක එය වගාකිරීමක් සිදුකරයි(Urine culture ABST).
මේ සදහා දින කිහිපයක් ගත විය හැක.
මෙමගින් ඇති බැක්ටීරියාව හදුනාගැනීම පහසුකරවන අතර ඊට උචිත ප්රථිජීවක ඖෂධ ගැනද තොරතුරු ලබා දේ.
මීට අමතරව ස්කෑන් පරීක්ෂණද බොහෝවිට සිදුකරනු ලබන අතර එය බොහොමයක් උත්පත්තියේදී මූත්රාමාර්ගය ආශ්රිතව ඇති වූ ව්යාකූලතා හදුනා ගැනීම උපකාරී වේ.
අවශ්යතාව අනුව සමහර අවස්ථාවලදී විශේෂිත එක්ස්-රේ පරීක්ෂණ සිදුකරනු ලබයි.
නමුත් මෙම පරීක්ෂණය බොහෝවිට විෂබීජ තත්වයට ප්රථිකාර කිරීමෙන් පසු කරනු ලැබේ.
එයද උත්පත්තියේදී ඇති වූ ව්යාකූල තත්වයන් හදුනා ගැනීමට ඉවහල් වන පරීක්ෂණයකි.
මෙවැනි තත්ව සදහා ප්රථිකාර කරනු ලබන්නේ කෙසේද?
වඩාත්ම සුදුසු ප්රථිජීවක ඹෟෂධය දෙනු ලැබේ.
එය නොකඩවා නියමිත මාත්රාවට අනුව ගතයුතුවේ.
මීට අමතරව හැකිතරම් වතුර බීමට උපදෙස් දෙනු ඇත.(ඉතාකුඩා දරුවෙක්නම් කිරි වැඩිපුර දිය යුතුය.)
උණ හා කැක්කුම පහව යාමට ඖෂධ ලබාදෙනු ඇත
ඖෂධ නියමිත මාත්රාව සම්පූර්ණ කල පසු නැවත දරුවා පරීක්ෂාකර බැලීම කරනු ඇත.
බොහෝ විට නැවත මුත්රා පරීක්ෂණ සිදුකර විෂබීජ නැති බව තහවුරු කරගැනීම කරනු ඇත.
මුත්රාමාර්ගයේ උත්පත්තියේ සිට ඇති වී ඇති සමහර අසාමාන්යතා ශල්යකර්ම මගින් යථා තත්වයට පත්කල යුතු වනු ඇත.
මූත්රා ආසාදන තත්වයන් ඇතිවීම වලක්වාගන්නේ කෙසේද?
දරුවාට මුත්රාතදකරගෙන සිටින්නේ නැතිව අවශ්යවිටදී මූත්රාකිරීමට උපදෙස් දීම.
හොදින් වතුර බීම.
යට ඇදුම් කලිසම් ආදිය ඉතාතදට ඇන්දවීමෙන් වැලකීම හා කපු ඇදුම් භාවිතා කිරීම.
මලබද්ධය ඇත්නම් වෛද්යවරයෙකු වෙත යොමු වී ඊට ප්රථිකාර ගැනීම.